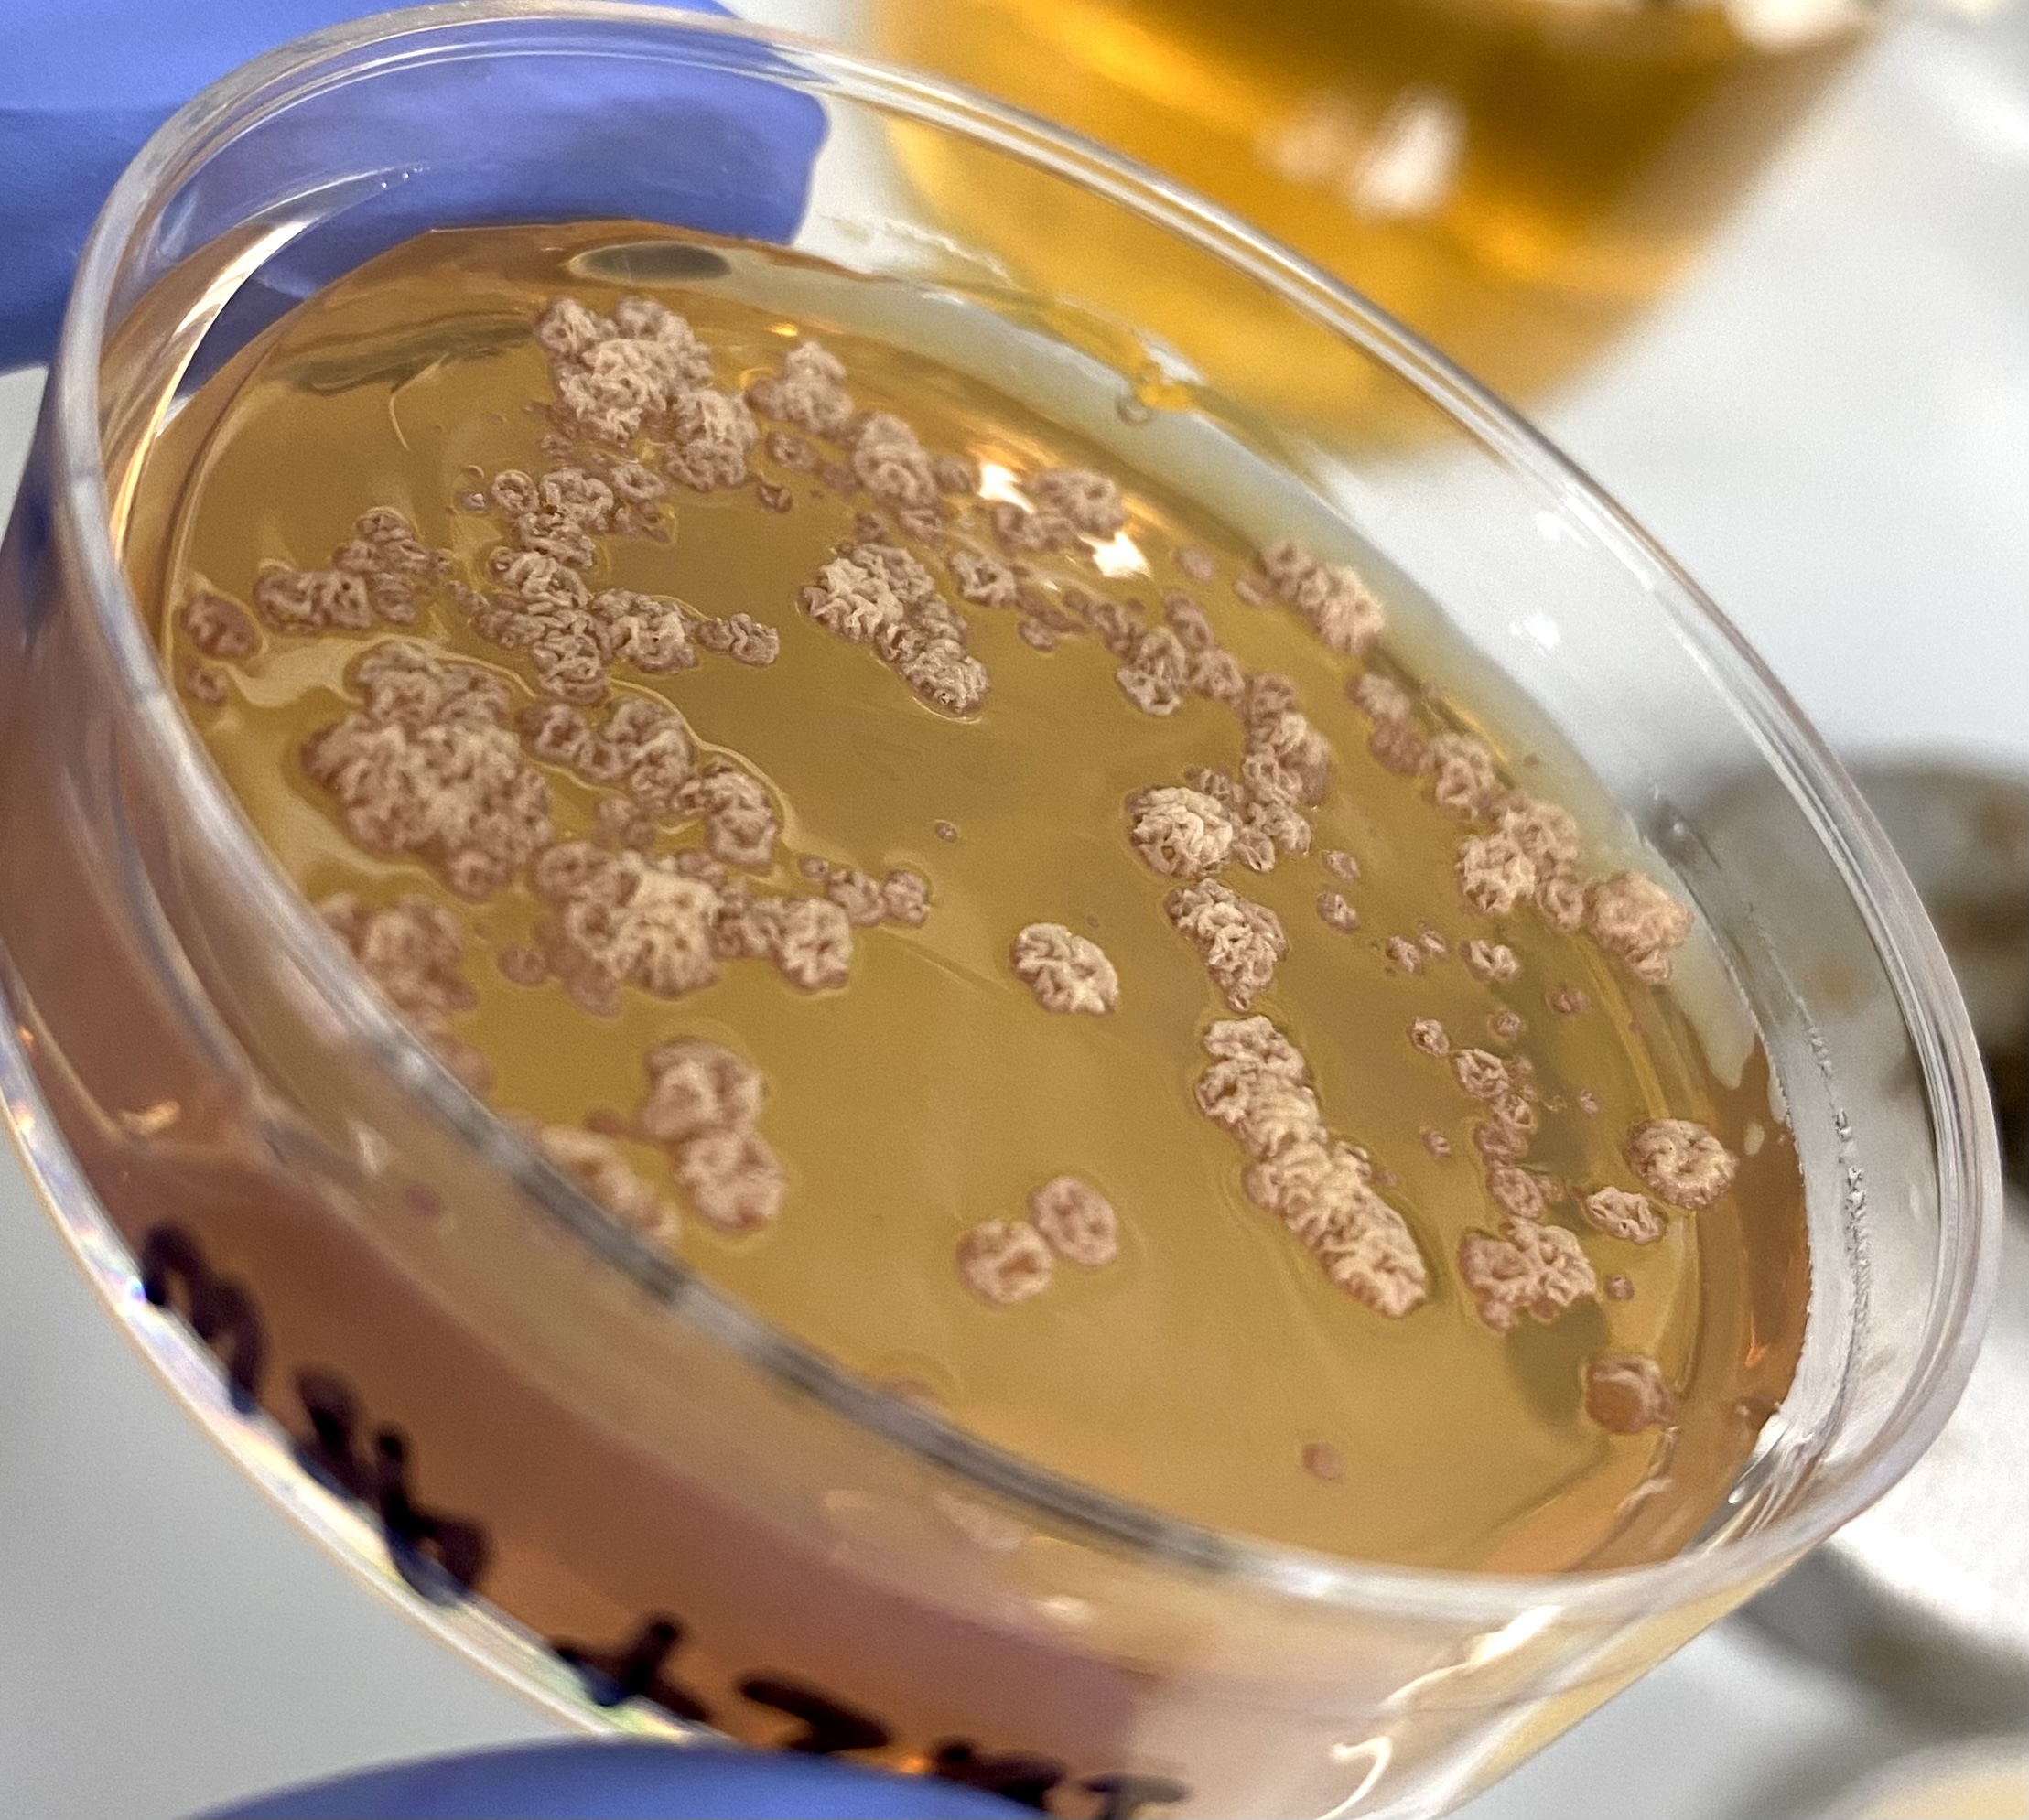
Lab research

Gallery
A collection of images from our research group.





























A collection of images from our research group.